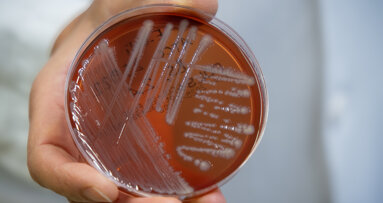
Freiburg researchers explore unknown oral bacteria in periodontitis research

NEW YORK, U.S.: The risks associated with poor oral health are many. In the past, scientists have demonstrated that around a third of colorectal cancers are associated with Fusobacterium nucleatum. In a new study, researchers at the Columbia University College of Dental Medicine, New York, have determined how F. nucleatumcan accelerate the growth of this cancer.
Colon cancer is the second leading cause of cancer-related deaths in the U.S. Researchers have long known that the disease is caused by genetic mutations that typically accumulate over the course of a decade. “Mutations are just part of the story,” according to study leader Dr. Yiping W. Han, Professor of Microbial Sciences at the Columbia University College of Dental Medicine and Vagelos College of Physicians and Surgeons. “Other factors, including microbes, can also play a role.”
In the study, the researchers found in cell cultures that noncancerous colon cells lack a protein called annexin A1, which stimulates cancer growth. They also discovered that F. nucleatum increases production of annexin A1, attracting more of the bacteria. They next confirmed that disabling annexin A1 prevented F. nucleatum from binding to the cancer cells, slowing their growth. “We identified a positive feedback loop that worsens the cancer’s progression,” said Han. “We propose a two-hit model, where genetic mutations are the first hit. F. nucleatum serves as the second hit, accelerating the cancer signaling pathway and speeding tumor growth.”
To further investigate their findings, the researchers then looked at an RNA-sequencing data set, available through the National Center for Biotechnology Information, of 466 patients with primary colon cancer. Patients with increased annexin A1 expression had a poorer prognosis, regardless of the cancer grade and stage, or their age or sex.
With the initial research results having recently been published, the scientists are now looking for ways to develop annexin A1 as a biomarker for more aggressive cancers and as a potential target for developing new treatments for colon and other types of cancer.
The study, titled “Fusobacterium nucleatum promotes colorectal cancer by inducing Wnt/β‐catenin modulator Annexin A1,” was published in EMBO reports on March 4, 2019.
Tags:
FAYETTEVILLE, Ark., U.S.: Food leaves permanent traces on teeth. Examining these marks—or microwear—a team of researchers has documented the effects of ...
NEW YORK, U.S.: Many people enjoy a drink, and now researchers from the New York University (NYU) School of Medicine have identified that alcohol ...
FREIBURG, Germany: Thousands of different bacteria colonise the oral cavity, many of which remain unidentified. Researchers in Freiburg are now using a ...
LONDON, England: Treatment of head and neck cancer is notoriously complex, and only few advances have been made in the last 20 years. Last month, however, ...
A graduate of Paris Descartes University (now the University of Paris), Dr Léon Pariente currently runs a private practice in the French capital that ...
ANKARA, Turkey: Given that the long-term performance of CAD/CAM restorative materials depends on both their intrinsic properties and response to staining ...
CHENGDU, China: Tooth root development depends on precise cell communication pathways. Researchers from China have shown how two genes, Gli2 and Gli3, work...
RUGBY, UK/BOISE, Idaho, US: Oral cancer incidence is on the rise globally and awareness of mouth cancer remains low. To tackle the issue, the Oral Health ...
BERN, Switzerland: As interest in plant-based milk alternatives continues to grow, more data is needed to understand their oral health implications in ...
MADRID, Spain/MEDELLÍN, Colombia: Researchers have evaluated the relationship between oral health-related quality of life (OHRQoL) and rheumatoid arthritis...
Live webinar
Mon. 22 June 2026
8:00 pm EST (New York)
Live webinar
Tue. 23 June 2026
1:00 pm EST (New York)
Live webinar
Tue. 23 June 2026
3:00 pm EST (New York)
Live webinar
Wed. 24 June 2026
8:00 am EST (New York)
Live webinar
Wed. 24 June 2026
11:00 am EST (New York)
Live webinar
Wed. 24 June 2026
12:30 pm EST (New York)
Dr. med. dent. Britta Hahn
Live webinar
Thu. 25 June 2026
2:00 pm EST (New York)
Dr. Hatem Algraffee, Cat Edney



 Austria / Österreich
Austria / Österreich
 Bosnia and Herzegovina / Босна и Херцеговина
Bosnia and Herzegovina / Босна и Херцеговина
 Bulgaria / България
Bulgaria / България
 Croatia / Hrvatska
Croatia / Hrvatska
 Czech Republic & Slovakia / Česká republika & Slovensko
Czech Republic & Slovakia / Česká republika & Slovensko
 France / France
France / France
 Germany / Deutschland
Germany / Deutschland
 Greece / ΕΛΛΑΔΑ
Greece / ΕΛΛΑΔΑ
 Hungary / Hungary
Hungary / Hungary
 Italy / Italia
Italy / Italia
 Netherlands / Nederland
Netherlands / Nederland
 Nordic / Nordic
Nordic / Nordic
 Poland / Polska
Poland / Polska
 Portugal / Portugal
Portugal / Portugal
 Romania & Moldova / România & Moldova
Romania & Moldova / România & Moldova
 Slovenia / Slovenija
Slovenia / Slovenija
 Serbia & Montenegro / Србија и Црна Гора
Serbia & Montenegro / Србија и Црна Гора
 Spain / España
Spain / España
 Switzerland / Schweiz
Switzerland / Schweiz
 Turkey / Türkiye
Turkey / Türkiye
 UK & Ireland / UK & Ireland
UK & Ireland / UK & Ireland
 Brazil / Brasil
Brazil / Brasil
 Canada / Canada
Canada / Canada
 Latin America / Latinoamérica
Latin America / Latinoamérica
 USA / USA
USA / USA
 China / 中国
China / 中国
 India / भारत गणराज्य
India / भारत गणराज्य
 Pakistan / Pākistān
Pakistan / Pākistān
 Vietnam / Việt Nam
Vietnam / Việt Nam
 ASEAN / ASEAN
ASEAN / ASEAN
 Israel / מְדִינַת יִשְׂרָאֵל
Israel / מְדִינַת יִשְׂרָאֵל
 Algeria, Morocco & Tunisia / الجزائر والمغرب وتونس
Algeria, Morocco & Tunisia / الجزائر والمغرب وتونس
 Middle East / Middle East
Middle East / Middle East

To post a reply please login or register